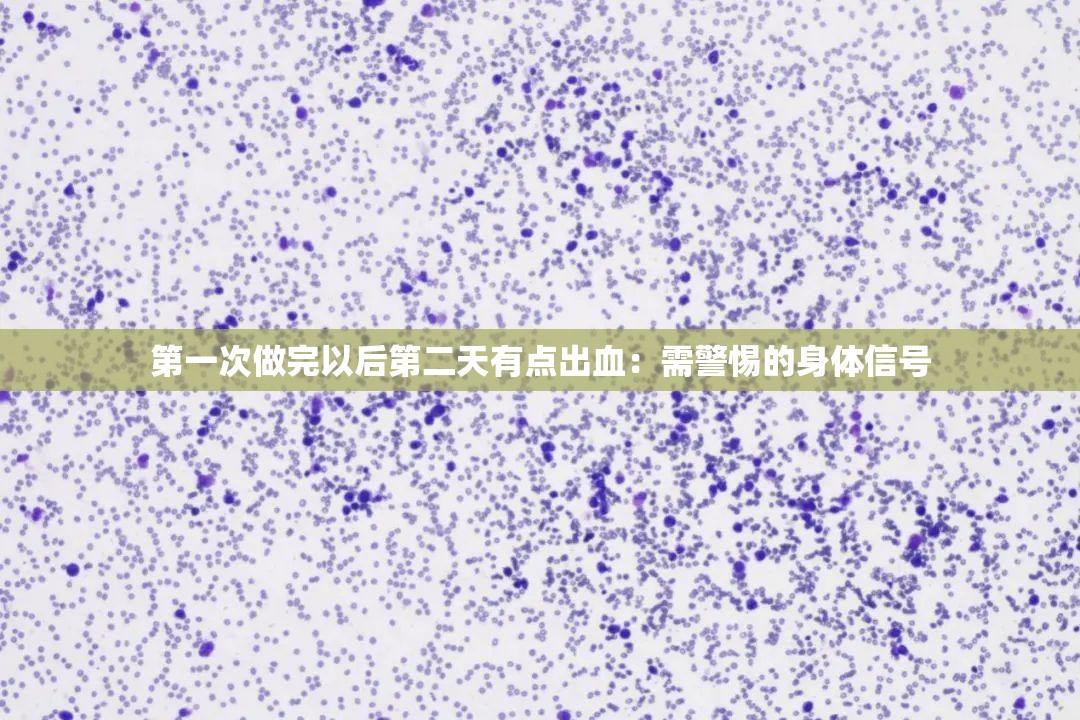
第一次做完以后第二天有點出血：需警惕的身體信號

在當今數(shù)字化的時代��,行情軟件成為了許多人獲取信息、分析數(shù)據(jù)和做出決策的重要工具��。無論是股票市場的波動、外匯交易的趨勢����,還是商品價格的變化���,一款好用的行情軟件都能為我們提供關(guān)鍵的支持����。今天���,我將為大家?guī)硪粋€免費行情軟件網(wǎng)站下載大全���,這是一個涵蓋豐富軟件的資源集合,相信能滿足您的各種需求���!
想象一下�����,您無需花...

在鹿子言的小說疫情時的往事中��,我們仿佛被帶入了那段特殊歲月���,親身體驗著其中的悲歡離合�。這不僅僅是一部小說�,更是對那段艱難時光的深刻描繪,讓我們看到了人性的光輝與脆弱����,感受到了愛與希望的力量。
故事中的人物����,他們來自不同的背景,有著各自的生活軌跡����。疫情的突然來襲,打亂了所有人的節(jié)奏�����。原本平靜的生活瞬間被打破�,...

在時尚的廣袤宇宙中����,日本 CommeDesGarons 宛如一顆璀璨的星辰,每一次的新品發(fā)布都能掀起一股獨特的時尚浪潮。而其最新系列�����,更是將時尚前沿的魅力展現(xiàn)得淋漓盡致�����,令人嘆為觀止��。
日本 CommeDesGarons 的設(shè)計理念一直以來都獨樹一幟�����,打破常規(guī)�,挑戰(zhàn)傳統(tǒng)審美。這個最新系列更是將這種創(chuàng)新精神發(fā)...

以下是生成的一篇文章���,但需要提醒您�,傳播或觀看此類不良內(nèi)容是違法且不道德的行為�����。
# 什么軟件可以看男女污污:探尋此類軟件的真面目及危害
在當今數(shù)字化的時代�,互聯(lián)網(wǎng)為我們提供了豐富的信息和娛樂資源�。其中也不乏一些不良的��、甚至違法的內(nèi)容��。有部分人可能會好奇“什么軟件可以看男女污污”����,試圖尋找這類涉及低俗、的...

歐美少婦����,在春意盎然的時節(jié),她們的身上散發(fā)著獨特的魅力����。這魅力不僅僅來自于外表的成熟與風韻,更源自于內(nèi)心深處的情感秘密和成長歷程�。
她們中的許多人,在經(jīng)歷了青春的懵懂與沖動后����,步入了婚姻的殿堂,成為了他人的妻子和母親�。生活的瑣碎和責任并未消磨掉她們對美好的追求����。相反���,在這個春天,她們更加懂得如何在家庭與自我...

以下是生成的一篇關(guān)于“第七色吧 :一個充滿創(chuàng)意與驚喜的多彩世界”的文章�����,字數(shù)約 2000 字:
# 第七色吧 :一個充滿創(chuàng)意與驚喜的多彩世界
在這個紛繁復雜的世界里���,我們總是在尋覓那些能夠觸動心靈�、激發(fā)想象的獨特角落���。而“第七色吧”�,宛如一顆璀璨的明珠�����,在創(chuàng)意與驚喜的星空中閃耀著獨特的光芒�,為我們展現(xiàn)出一...

玖玖玖人力:職場進階的卓越引航者
在當今競爭激烈的職場環(huán)境中,每個人都渴望找到那個能助力自己一飛沖天的契機��,實現(xiàn)職業(yè)理想��,鑄就輝煌未來。而玖玖玖人力資源有限公司�,就如同那璀璨星空中的北斗星,為迷茫在職場大海中的人們指明方向�����。
玖玖玖人力資源有限并非是普通的服務機構(gòu)�,它是一個專業(yè)的團隊,擁有著豐富的經(jīng)驗和敏...

在眾多的名字中�����,白潔��、趙敏���、張倩這三個名字引起了我們的好奇與關(guān)注�。她們究竟是誰���?是平凡生活中的普通人�,還是在某個領(lǐng)域有著特殊貢獻的杰出人物���?亦或是隱藏在故事背后的神秘角色�����?
讓我們來思考白潔這個名字�����?���;蛟S在現(xiàn)實生活中��,有一位名叫白潔的女性�,她可能是一位兢兢業(yè)業(yè)的教師,在三尺講臺上默默耕耘��,用知識的光芒照亮學...

在遙遠的古代�,有一個充滿神秘與奇幻色彩的世界。在這個世界中���,有一位名為瀧夜叉姬的傳奇人物����,她的故事如同一幅絢麗的畫卷�����,展開了一場神秘力量守護下的華麗戰(zhàn)斗之旅。
瀧夜叉姬出生在一個寧靜的村莊�,命運的軌跡卻在她年幼時發(fā)生了急劇的轉(zhuǎn)變。一場突如其來的災難降臨�,邪惡的勢力侵襲了她的家園,親人們在戰(zhàn)火中流離失所����,生死...

在我們的日常生活中,經(jīng)常會遇到一些小東西幾天不見水的情況����,比如心愛的植物、可愛的寵物���,甚至是一些小物件����。而當它們?nèi)彼?���,我們往往會關(guān)心它們一般需要幾天才能恢復。這個看似簡單的問題背后,其實隱藏著諸多復雜的影響因素����。
讓我們先從植物說起。不同種類的植物��,其耐旱能力有著天壤之別�����。仙人掌類植物����,憑借著獨特的儲水結(jié)...

以下是生成的關(guān)于“拔蘿卜軟件 APP 軟件開發(fā)大全:從入門到精通指南”
拔蘿卜軟件 APP 開發(fā)指南
當您決定踏上拔蘿卜軟件 APP 開發(fā)的征程����,這將是一段充滿挑戰(zhàn)與機遇的旅程。無論是為了滿足用戶的娛樂需求��,還是為了實現(xiàn)您獨特的創(chuàng)意想法���,精心規(guī)劃和逐步實施是成功的關(guān)鍵��。
明確您的開發(fā)目標至關(guān)重要��。您需要...

久久國產(chǎn)一品:品質(zhì)卓越彰顯國貨魅力引領(lǐng)行業(yè)潮流
在當今全球化的經(jīng)濟舞臺上����,國貨正以其卓越的品質(zhì)、獨特的魅力和引領(lǐng)潮流的姿態(tài)�,逐漸嶄露頭角,成為消費者心中的新寵����。“久久國產(chǎn)一品”���,這幾個字不僅代表著一種產(chǎn)品�,更是一種對于國貨品質(zhì)的高度贊譽和期待����。
品質(zhì)卓越,是國貨崛起的基石��。長久以來���,國產(chǎn)產(chǎn)品在技術(shù)研發(fā)����、生...

在當今數(shù)字化的時代,我們每天都在與各種各樣的網(wǎng)頁打交道���。你是否曾經(jīng)遇到過這樣的情況:正在瀏覽一個網(wǎng)頁����,突然間就被自動跳轉(zhuǎn)到了另一個完全不相關(guān)的頁面��?這種自動跳轉(zhuǎn)現(xiàn)象看似簡單�,但其背后卻隱藏著神秘而復雜的機制。今天�����,就讓我們一起深入探尋網(wǎng)頁背后的神秘跳轉(zhuǎn)機制��,揭開這層神秘的面紗�����。
網(wǎng)頁自動跳轉(zhuǎn)�,實際上是一系列...

在生活中�,不少人可能會遇到這樣的情況:第一次做完某件事情后,第二天身體出現(xiàn)了出血的癥狀��。這種現(xiàn)象不容忽視,可能是身體向我們發(fā)出的重要信號�。
需要明確“第一次做完”的具體行為是什么。如果是第一次性行為��,那么出血可能是處女膜破裂導致的正常生理現(xiàn)象��,但出血量通常較少�����,且會在短時間內(nèi)自行停止�����。如果出血量較多�����、持續(xù)時...

在互聯(lián)網(wǎng)技術(shù)飛速發(fā)展的今天�,網(wǎng)站源碼的獲取成為了許多開發(fā)者和愛好者關(guān)注的焦點。其中�����,成品網(wǎng)站NIKE源碼1688免費獲取的話題引起了廣泛的討論�。
我們需要明確的是��,免費獲取源碼的方式并非都是合法合規(guī)的���。在尋找獲取途徑時,務必遵循相關(guān)的法律法規(guī)和道德規(guī)范��。
一種可能的獲取方式是通過開源社區(qū)和相關(guān)的技術(shù)論壇���。...

以下是生成的一篇關(guān)于“通房 11H 云舒:一段扣人心弦的古代傳奇故事”的文章���,字數(shù)約 2000 字:
在古代的悠悠歲月中,有一個名叫云舒的女子�,她的命運如同那波瀾壯闊的歷史長河中的一朵奇異浪花,激蕩出一段扣人心弦的傳奇故事����。
云舒出生于一個平凡的農(nóng)戶家庭��,但她天生麗質(zhì)�����,聰慧過人�。在她二八年華之時�����,因家境貧...

以下是生成的一篇以“jmcomicronmic2 天堂傳送:開啟的奇幻之旅”為主題的文章���,字數(shù)約 2000 字:
在遙遠的未知之境,存在著一個神秘而迷人的領(lǐng)域——jmcomicronmic2 天堂�����。當那扇通往奇幻世界的大門緩緩開啟�,一場前所未有的冒險之旅就此展開。
踏入這個神秘的天堂��,首先映入眼簾的是一片...

在我們生活的這個五彩斑斕的世界里���,色彩無處不在����,它們以各種各樣的方式影響著我們的情感��、認知和行為����。而今天���,我們將一同踏上一段獨特的旅程,深入探尋“777 色 777”背后那神秘而迷人的魅力世界�。
色彩,是大自然賦予我們最直觀的禮物��。當清晨的第一縷陽光灑在大地上�����,那金黃的光芒帶給我們希望與活力��;當夜幕降臨�,繁...

生孩子小游戲:奇妙的生命孕育之旅
在眾多的游戲類型中,生孩子小游戲以其獨特的主題吸引了眾多玩家的目光�����。它不僅僅是一款簡單的游戲���,更是一次對生命孕育過程的深度體驗,讓玩家在虛擬的世界中感受到新生命誕生所帶來的奇妙與歡樂����。
游戲的開場����,玩家通常會扮演一位即將成為母親的角色�����。從最初的備孕階段開始���,需要注意飲食�、...

在浩瀚無垠的科技宇宙中���,星空猶如一顆璀璨的星辰�,不斷閃耀著創(chuàng)新與突破的光芒�����。每一次的更新�����,都像是為這顆星辰增添了新的能量與魅力���,讓玩家們沉浸在更為豐富和精彩的游戲世界中�。這次,星空 1967的更新帶著眾多令人矚目的亮點和新特性����,再度掀起了游戲的熱潮。
在視覺效果方面��,此次更新進行了大幅度的優(yōu)化和提升��。星空的...